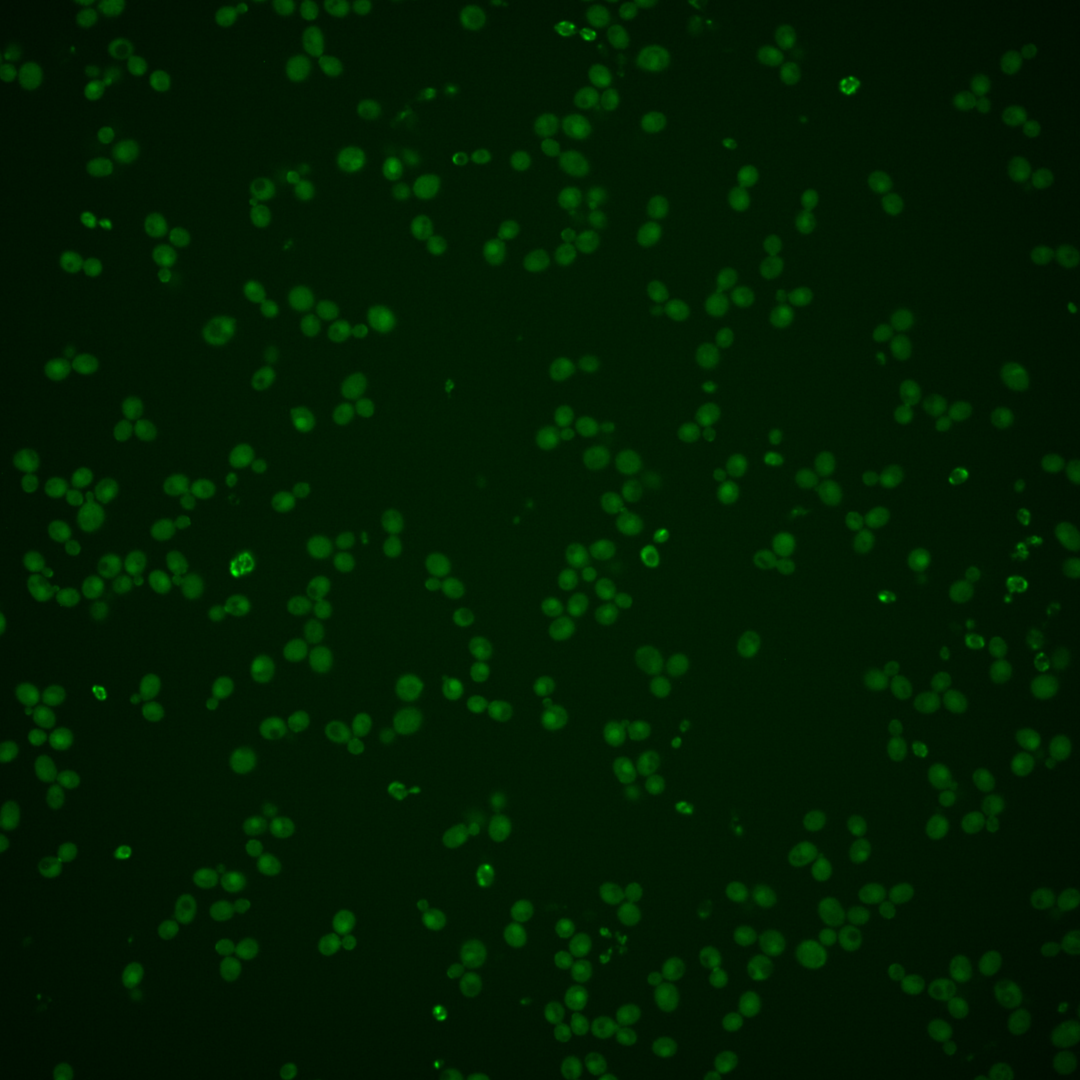
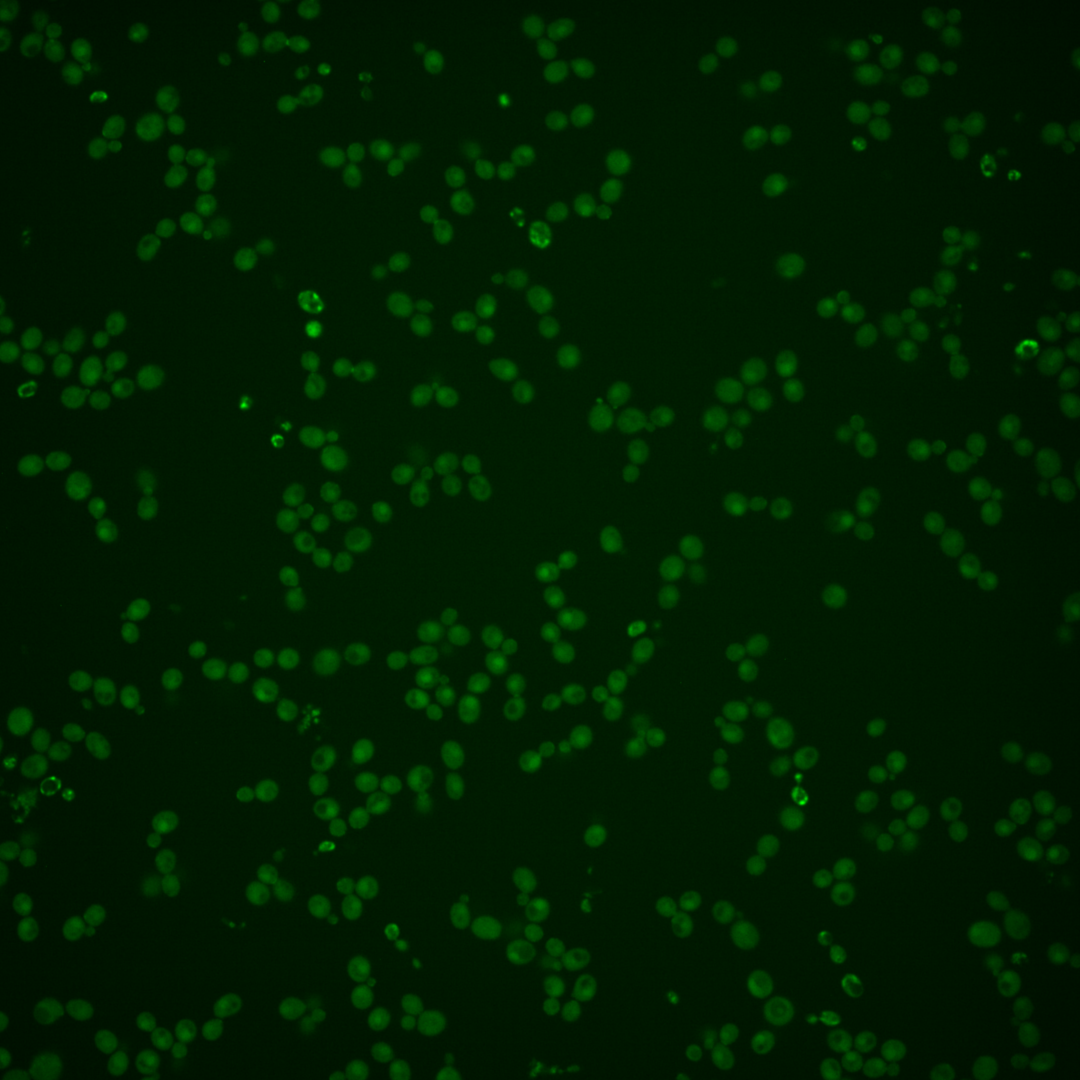
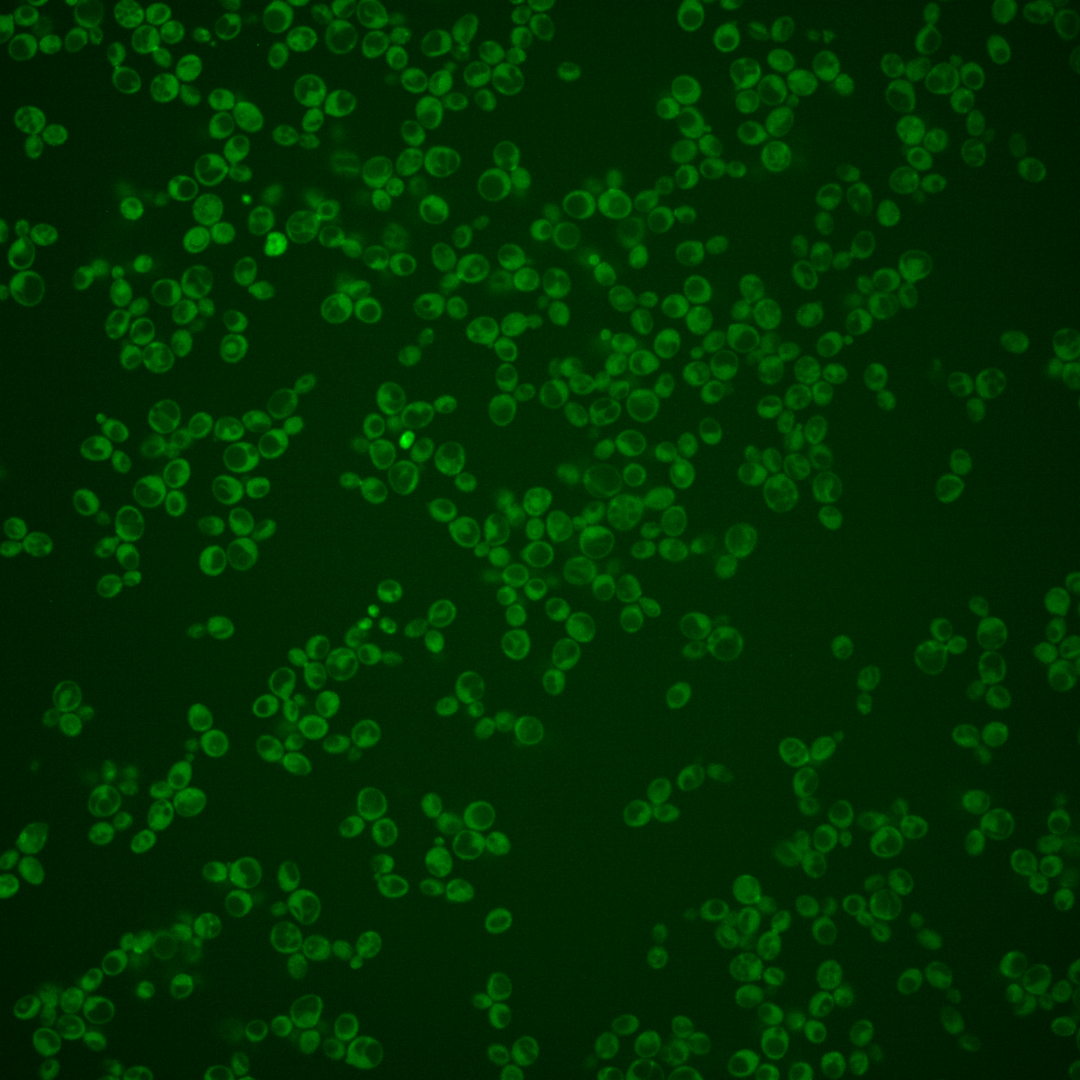
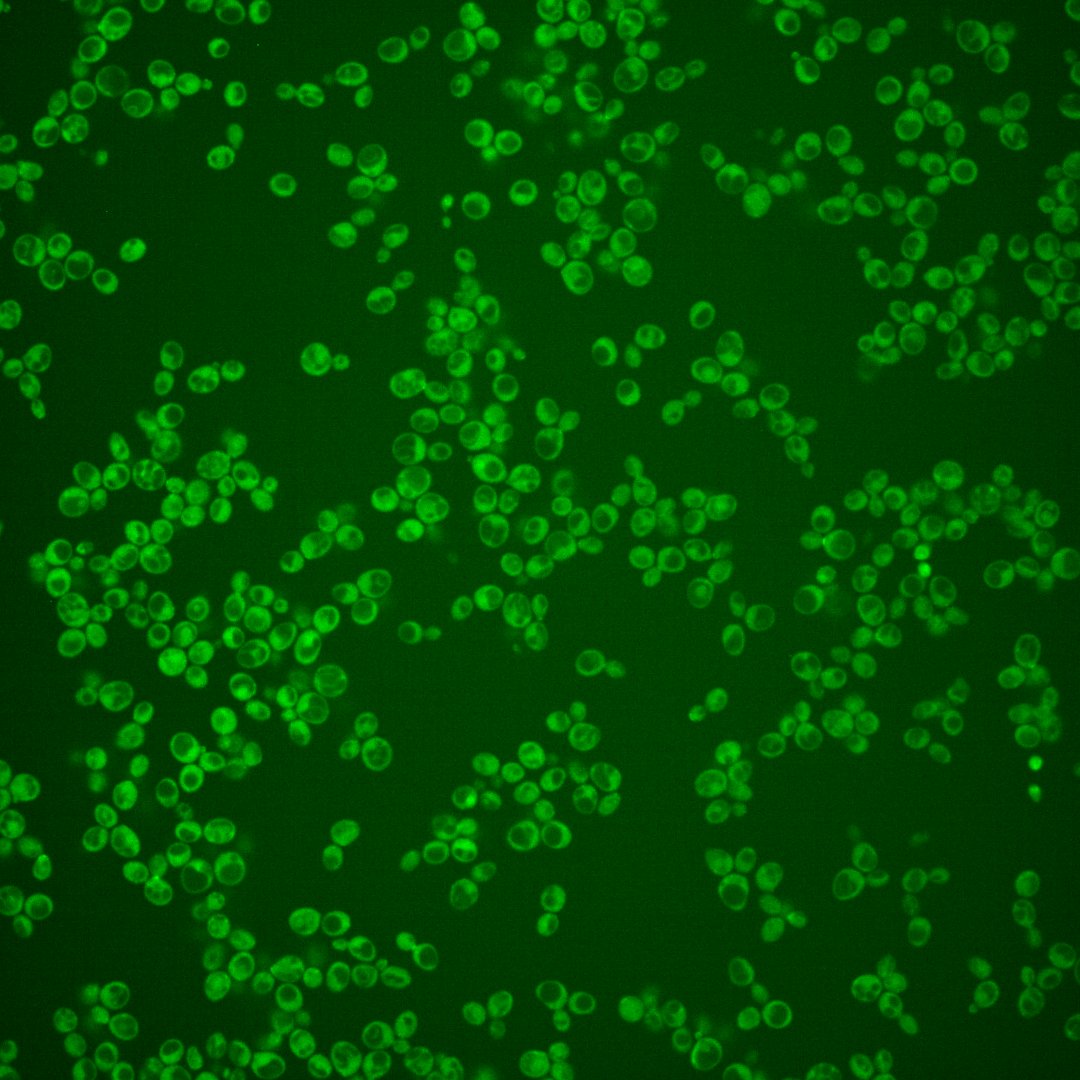

| Standard name | |
|---|---|
| Human Ortholog | |
| Description | S/T protein kinase; regulates polarized exocytosis and the Ire1p-mediated UPR; regulates HAC1 mRNA translocation, splicing and translation with KIN1 during ER stress; direct phosphorylation of Sec9p (S190) is enhanced by prior substrate priming (S192); localizes to the cytoplasmic face of the PM and sites of polarized growth; may regulate septin and cell wall organization; activation loop phosphorylation (T281) required for full kinase activity; orthologous to MARK/PAR-1, AMPK family members |
Micrographs




















































































Sub-cellular Localization
Yeast GFP Assignment
Protein Abundance
Localization Change
External localization resources
| ensLOC | DeepLoc | |||||||||||||||||||||||
|---|---|---|---|---|---|---|---|---|---|---|---|---|---|---|---|---|---|---|---|---|---|---|---|---|
| Localization | WT1 | WT2 | WT3 | RAP60 | RAP140 | RAP220 | RAP300 | RAP380 | RAP460 | RAP540 | RAP620 | RAP700 | HU80 | HU120 | HU160 | rpd3Δ_1 | rpd3Δ_2 | rpd3Δ_3 | WT1 | WT2 | WT3 | AF100 | AF140 | AF180 |
| Cortical Patches | 2 | 15 | 2 | 0 | 1 | 0 | 0 | 0 | – | 0 | 1 | 1 | 3 | 2 | 4 | 12 | 19 | 36 | 27 | 13 | 24 | 27 | 32 | 13 |
| Bud | 4 | 8 | 12 | 5 | 4 | 11 | 13 | 21 | – | 24 | 18 | 22 | 1 | 2 | 3 | 4 | 5 | 15 | 13 | 6 | 8 | 35 | 17 | 9 |
| Bud Neck | 0 | 0 | 1 | 0 | 0 | 0 | 0 | 1 | – | 0 | 0 | 0 | 3 | 2 | 0 | 4 | 8 | 0 | 45 | 16 | 36 | 37 | 21 | 12 |
| Bud Site | 0 | 1 | 1 | 0 | 0 | 1 | 0 | 1 | – | 2 | 1 | 1 | 0 | 0 | 0 | 2 | 2 | 3 | – | – | – | – | – | – |
| Cell Periphery | 45 | 10 | 15 | 14 | 10 | 12 | 15 | 4 | – | 10 | 21 | 17 | 18 | 10 | 15 | 14 | 9 | 23 | 7 | 3 | 10 | 5 | 6 | 6 |
| Cytoplasm | 381 | 237 | 324 | 323 | 320 | 463 | 555 | 591 | – | 452 | 363 | 427 | 155 | 159 | 286 | 512 | 389 | 301 | 373 | 213 | 242 | 82 | 241 | 297 |
| Endoplasmic Reticulum | 0 | 7 | 0 | 1 | 3 | 2 | 6 | 0 | – | 2 | 3 | 4 | 5 | 2 | 2 | 30 | 17 | 22 | 20 | 2 | 13 | 7 | 8 | 12 |
| Endosome | 21 | 0 | 5 | 0 | 5 | 4 | 4 | 11 | – | 9 | 5 | 6 | 0 | 0 | 0 | 1 | 0 | 2 | 9 | 6 | 8 | 3 | 4 | 4 |
| Golgi | 0 | 0 | 0 | 0 | 0 | 0 | 0 | 0 | – | 0 | 0 | 0 | 0 | 0 | 0 | 0 | 0 | 0 | 4 | 1 | 1 | 1 | 2 | 2 |
| Mitochondria | 11 | 8 | 12 | 20 | 36 | 116 | 190 | 279 | – | 287 | 237 | 320 | 0 | 0 | 0 | 43 | 19 | 10 | 9 | 6 | 17 | 16 | 18 | 10 |
| Nucleus | 1 | 1 | 0 | 1 | 0 | 0 | 2 | 4 | – | 5 | 2 | 4 | 0 | 0 | 0 | 2 | 5 | 1 | 0 | 1 | 0 | 0 | 0 | 0 |
| Nuclear Periphery | 1 | 0 | 0 | 0 | 0 | 0 | 0 | 4 | – | 0 | 0 | 1 | 0 | 0 | 0 | 0 | 0 | 0 | 0 | 0 | 0 | 0 | 0 | 1 |
| Nucleolus | 2 | 0 | 1 | 1 | 0 | 0 | 3 | 1 | – | 2 | 2 | 0 | 0 | 0 | 0 | 0 | 0 | 0 | 1 | 0 | 0 | 0 | 1 | 0 |
| Peroxisomes | 4 | 1 | 9 | 2 | 4 | 0 | 2 | 1 | – | 0 | 0 | 0 | 0 | 0 | 0 | 0 | 0 | 5 | 0 | 0 | 0 | 0 | 0 | 0 |
| SpindlePole | 13 | 0 | 7 | 1 | 3 | 1 | 5 | 3 | – | 3 | 3 | 0 | 0 | 0 | 0 | 8 | 9 | 14 | 2 | 0 | 1 | 1 | 1 | 1 |
| Vac/Vac Membrane | 4 | 0 | 1 | 0 | 8 | 3 | 7 | 15 | – | 5 | 9 | 15 | 0 | 0 | 1 | 1 | 0 | 5 | 7 | 5 | 5 | 5 | 7 | 14 |
| Unique Cell Count | 422 | 264 | 359 | 334 | 352 | 517 | 668 | 763 | 631 | 517 | 653 | 159 | 161 | 294 | 554 | 425 | 367 | 529 | 280 | 379 | 228 | 370 | 392 | |
| Labelled Cell Count | 489 | 288 | 390 | 368 | 394 | 613 | 802 | 936 | 801 | 665 | 818 | 185 | 177 | 311 | 633 | 482 | 437 | 529 | 280 | 379 | 228 | 370 | 392 | |
Yeast GFP Assignment
Protein Abundance
| Screen | WT1 | WT2 | WT3 | RAP60 | RAP140 | RAP220 | RAP300 | RAP380 | RAP460 | RAP540 | RAP620 | RAP700 | HU80 | HU120 | HU160 | rpd3Δ_1 | rpd3Δ_2 | rpd3Δ_3 | AF100 | AF140 | AF180 |
|---|---|---|---|---|---|---|---|---|---|---|---|---|---|---|---|---|---|---|---|---|---|
| Mean Cell GFP Intensity (1e-4) | 5.9 | 5.9 | 4.8 | 5.0 | 4.6 | 4.0 | 4.1 | 4.1 | – | 3.7 | 3.7 | 3.8 | 6.6 | 6.6 | 7.0 | 4.9 | 5.1 | 6.9 | 6.9 | 6.9 | 7.0 |
| Std Deviation (1e-4) | 0.6 | 0.8 | 0.8 | 1.2 | 1.2 | 1.0 | 1.2 | 0.8 | – | 1.2 | 0.9 | 0.9 | 0.9 | 0.9 | 1.0 | 1.0 | 0.8 | 1.2 | 1.5 | 1.4 | 1.6 |
| Intensity Change (Log2) | – | – | – | 0.06 | -0.04 | -0.24 | -0.24 | -0.24 | – | -0.37 | -0.38 | -0.32 | 0.46 | 0.46 | 0.54 | 0.04 | 0.09 | 0.52 | 0.53 | 0.53 | 0.55 |
Localization Change
| Localization | RAP60 | RAP140 | RAP220 | RAP300 | RAP380 | RAP460 | RAP540 | RAP620 | RAP700 | HU80 | HU120 | HU160 | rpd3Δ_1 | rpd3Δ_2 | rpd3Δ_3 |
|---|---|---|---|---|---|---|---|---|---|---|---|---|---|---|---|
| Cortical Patches | 0 | 0 | 0 | 0 | 0 | – | 0 | 0 | 0 | 0 | 0 | 0 | 1.9 | 3.4 | 5.6 |
| Bud | -1.6 | 0 | 0 | 0 | 0 | – | 0 | 0 | 0 | 0 | 0 | -2.0 | -2.9 | -2.1 | 0.5 |
| Bud Neck | 0 | 0 | 0 | 0 | 0 | – | 0 | 0 | 0 | 0 | 0 | 0 | 0 | 0 | 0 |
| Bud Site | 0 | 0 | 0 | 0 | 0 | – | 0 | 0 | 0 | 0 | 0 | 0 | 0 | 0 | 0 |
| Cell Periphery | 0 | 0 | 0 | 0 | 0 | – | 0 | 0 | 0 | 3.1 | 1.0 | 0.6 | -1.4 | -1.7 | 1.3 |
| Cytoplasm | 3.4 | 0.3 | -0.3 | -3.1 | -5.2 | – | -6.8 | -7.1 | -8.6 | 2.9 | 3.5 | 3.6 | 1.2 | 0.6 | -3.2 |
| Endoplasmic Reticulum | 0 | 0 | 0 | 0 | 0 | – | 0 | 0 | 0 | 0 | 0 | 0 | 4.5 | 3.8 | 4.7 |
| Endosome | 0 | 0 | 0 | 0 | 0 | – | 0 | 0 | 0 | 0 | 0 | 0 | 0 | 0 | 0 |
| Golgi | 0 | 0 | 0 | 0 | 0 | – | 0 | 0 | 0 | 0 | 0 | 0 | 0 | 0 | 0 |
| Mitochondria | 1.7 | 0 | 0 | 0 | 0 | – | 0 | 0 | 0 | 0 | 0 | -3.2 | 2.7 | 0.8 | -0.5 |
| Nucleus | 0 | 0 | 0 | 0 | 0 | – | 0 | 0 | 0 | 0 | 0 | 0 | 0 | 0 | 0 |
| Nuclear Periphery | 0 | 0 | 0 | 0 | 0 | – | 0 | 0 | 0 | 0 | 0 | 0 | 0 | 0 | 0 |
| Nucleolus | 0 | 0 | 0 | 0 | 0 | – | 0 | 0 | 0 | 0 | 0 | 0 | 0 | 0 | 0 |
| Peroxisomes | -2.0 | 0 | 0 | 0 | 0 | – | 0 | 0 | 0 | 0 | 0 | 0 | 0 | 0 | -1.1 |
| SpindlePole | 0 | 0 | 0 | 0 | 0 | – | 0 | 0 | 0 | 0 | 0 | 0 | -0.6 | 0.2 | 1.5 |
| Vacuole | 0 | 0 | 0 | 0 | 2.2 | – | 0 | 0 | 2.5 | 0 | 0 | 0 | 0 | 0 | 0 |
External localization resources
Images






























Protein Concentration and Protein Localization Data
| R1 | R2 | R3 | ||||||||||||||||
|---|---|---|---|---|---|---|---|---|---|---|---|---|---|---|---|---|---|---|
| G1 Pre-START | G1 Post-START | S/G2 | Metaphase | Anaphase | Telophase | G1 Pre-START | G1 Post-START | S/G2 | Metaphase | Anaphase | Telophase | G1 Pre-START | G1 Post-START | S/G2 | Metaphase | Anaphase | Telophase | |
| Concentration | – | – | – | – | – | – | – | – | – | – | – | – | – | – | – | – | – | – |
| Actin | 0.031 | 0.0024 | 0.0294 | 0.0319 | 0.0726 | 0.0183 | 0.0582 | 0.0041 | 0.032 | 0.0489 | 0.023 | 0.0184 | – | – | – | – | – | – |
| Bud | 0.0033 | 0.0065 | 0.0181 | 0.0122 | 0.0018 | 0.0032 | 0.0029 | 0.0025 | 0.0215 | 0.0105 | 0.0061 | 0.0008 | – | – | – | – | – | – |
| Bud Neck | 0.009 | 0.0012 | 0.0052 | 0.0028 | 0.0246 | 0.1718 | 0.0092 | 0.0018 | 0.0009 | 0.0081 | 0.0014 | 0.22 | – | – | – | – | – | – |
| Bud Periphery | 0.0078 | 0.0083 | 0.0535 | 0.0464 | 0.0038 | 0.0046 | 0.0076 | 0.0016 | 0.0538 | 0.0422 | 0.0267 | 0.0021 | – | – | – | – | – | – |
| Bud Site | 0.0265 | 0.0538 | 0.029 | 0.0033 | 0.0014 | 0.004 | 0.0305 | 0.1016 | 0.0039 | 0.0147 | 0.0027 | 0.0027 | – | – | – | – | – | – |
| Cell Periphery | 0.0063 | 0.0044 | 0.004 | 0.0033 | 0.0011 | 0.0023 | 0.0121 | 0.0028 | 0.0039 | 0.0058 | 0.0061 | 0.002 | – | – | – | – | – | – |
| Cytoplasm | 0.5877 | 0.7837 | 0.6742 | 0.7756 | 0.6778 | 0.6564 | 0.611 | 0.8044 | 0.6671 | 0.6378 | 0.6784 | 0.6388 | – | – | – | – | – | – |
| Cytoplasmic Foci | 0.0354 | 0.0115 | 0.0172 | 0.0129 | 0.0309 | 0.0157 | 0.0375 | 0.0127 | 0.0185 | 0.0203 | 0.0296 | 0.0056 | – | – | – | – | – | – |
| Eisosomes | 0.0004 | 0.0001 | 0.0003 | 0.0002 | 0.0005 | 0.0002 | 0.0008 | 0.0001 | 0.0005 | 0.0009 | 0.0003 | 0.0001 | – | – | – | – | – | – |
| Endoplasmic Reticulum | 0.0146 | 0.0044 | 0.0053 | 0.0075 | 0.0115 | 0.0056 | 0.0096 | 0.0043 | 0.0059 | 0.003 | 0.0045 | 0.0019 | – | – | – | – | – | – |
| Endosome | 0.0298 | 0.006 | 0.0163 | 0.0246 | 0.0463 | 0.0101 | 0.018 | 0.0041 | 0.015 | 0.0226 | 0.0047 | 0.0065 | – | – | – | – | – | – |
| Golgi | 0.0058 | 0.0013 | 0.0054 | 0.0053 | 0.0147 | 0.0025 | 0.0148 | 0.0015 | 0.0077 | 0.0095 | 0.0044 | 0.0032 | – | – | – | – | – | – |
| Lipid Particles | 0.0052 | 0.0006 | 0.002 | 0.0014 | 0.0204 | 0.0012 | 0.0123 | 0.0017 | 0.007 | 0.0127 | 0.0122 | 0.001 | – | – | – | – | – | – |
| Mitochondria | 0.0075 | 0.0004 | 0.0039 | 0.0033 | 0.0029 | 0.0011 | 0.0036 | 0.0001 | 0.0095 | 0.0034 | 0.0031 | 0.0118 | – | – | – | – | – | – |
| None | 0.167 | 0.1074 | 0.1165 | 0.0544 | 0.0381 | 0.0874 | 0.1364 | 0.0514 | 0.1321 | 0.1431 | 0.1217 | 0.0808 | – | – | – | – | – | – |
| Nuclear Periphery | 0.0225 | 0.0006 | 0.0072 | 0.0019 | 0.006 | 0.0065 | 0.0017 | 0.0005 | 0.002 | 0.0011 | 0.0019 | 0.0012 | – | – | – | – | – | – |
| Nucleolus | 0.0011 | 0.0003 | 0.0003 | 0.0002 | 0.0009 | 0.0003 | 0.0004 | 0.0001 | 0.0002 | 0.0006 | 0.004 | 0.0001 | – | – | – | – | – | – |
| Nucleus | 0.0142 | 0.0019 | 0.0023 | 0.0017 | 0.0241 | 0.0029 | 0.001 | 0.0008 | 0.001 | 0.0013 | 0.0025 | 0.0006 | – | – | – | – | – | – |
| Peroxisomes | 0.0045 | 0.0002 | 0.0021 | 0.0021 | 0.0074 | 0.0007 | 0.0221 | 0.0002 | 0.0127 | 0.0056 | 0.054 | 0.0007 | – | – | – | – | – | – |
| Punctate Nuclear | 0.0119 | 0.0006 | 0.0022 | 0.0012 | 0.0075 | 0.002 | 0.0061 | 0.0008 | 0.0017 | 0.0035 | 0.0103 | 0.0005 | – | – | – | – | – | – |
| Vacuole | 0.0066 | 0.0039 | 0.0046 | 0.0067 | 0.0047 | 0.0025 | 0.0035 | 0.0029 | 0.0026 | 0.0038 | 0.0018 | 0.001 | – | – | – | – | – | – |
| Vacuole Periphery | 0.0021 | 0.0002 | 0.001 | 0.0011 | 0.001 | 0.0005 | 0.0005 | 0.0002 | 0.0006 | 0.0006 | 0.0005 | 0.0003 | – | – | – | – | – | – |
Sequencing Data
| R1 | R2 | |||||||||
|---|---|---|---|---|---|---|---|---|---|---|
| G1 Post-START | S/G2 | Metaphase | Anaphase | Telophase | G1 Post-START | S/G2 | Metaphase | Anaphase | Telophase | |
| Gene Expression | 18.5823 | 16.6114 | 15.9393 | 26.9272 | 22.8466 | 18.572 | 23.0942 | 24.2357 | 24.5365 | 27.6109 |
| Translational Efficiency | 0.8695 | 0.7716 | 0.8429 | 0.4577 | 0.5582 | 0.8693 | 0.6385 | 0.5414 | 0.5531 | 0.5602 |
Hit Data
| Dataset | Hit |
|---|---|
| Protein Concentration | – |
| Protein Localization | ✘ |
| Gene Expression | ✘ |
| Translational Efficiency | ✘ |
Endocytosis
| Temp | Actin Patch (Sac6-tdTomato) | Cortical Patch (Sla1-GFP) | Late Endosome (Snf7-GFP) | Vacuole (Vph1-GFP) |
|---|---|---|---|---|
| 37℃ | ||||
| RT |
Cell Cycle Omics
CYCLoPs (Kin2-GFP)
| Gene / Allele | Actin Patch (Sac6-tdTomato) | Cortical Patch (Sla1-GFP) | Late Endosome (Snf7-GFP) | Vacuole (Sac6-tdTomato) |
|---|
| Gene | Images |
|---|
| Gene | Images |
|---|
Images are not yet available
Images are not yet available